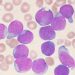
Hallado un mecanismo que inhibe un tipo de leucemia en ratones

La séptima edición del “Festival de Cortos de La Nucía, CortoEspaña” será on-line por la pandemia de la COVID-19, sin proyecciones en l’Auditori. Los 10 cortos a concurso estarán disponibles mediante acceso online, del 19 hasta el 29 de noviembre, de forma gratuita. El ganador de este certamen de cortometrajes lo decidirán los espectadores del festival con su voto digital.
El VII Festival de Cortos de La Nucía, CortoEspaña será on-line y no habrá proyecciones presenciales como en las ediciones anteriores. Este Festival está organizado por la concejalía de Cultura del Ayuntamiento de La Nucía y CortoEspaña. En esta séptima edición el público seguirá designando el ganador del certamen, pero su votación será digital, en vez de en papel como los años anteriores. En total habrá 10 cortometrajes a “concurso”, los más galardonados en los “Premios Fugaz 2020” de CortoEspaña
Festival online gratuito
Todos los cortos se podrán ver de forma digital del 19 al 29 de noviembre, de forma gratuita, cada espectador desde su “casa”. Los espectadores podrán votar para el Premio del Público del VII Festival de Cortos de La Nucía, organizado un año más con CortoEspaña.
Los 10 cortos se podrán visionar, a través de Internet, de forma gratuita durante 10 días (del 19 al 29 de noviembre). Son los 10 cortometrajes más galardonados en los Premios Fugaz 2020. Son cortometrajes de gran calidad, artística y técnica, muy atractivos para los espectadores, que se darán a conocer la próxima semana, junto con el enlace para visionarlos
Votación público: corto ganador
Los espectadores del festival de esta edición podrán votar y premiar el mejor corto, desde sus casas, tras visionar los 10 cortometrajes a concurso. Esta edición será toda on-line y no habrá ninguna proyección, ni acto presencial.
“Disfrutar desde casa”
“Por séptimo año consecutivo, organizamos el Festival de Cortos de La Nucía junto con CortoEspaña. Esta edición de 2020, por causa de la pandemia será digital sin proyecciones presenciales. Por tanto se trata de disfrutar desde casa, con la manta y en el sofá, de los 10 cortometrajes a concurso. El público tendrá 10 días para visionar los cortos de forma on-line y votar al mejor corto 2020. Del 19 al 29 de noviembre tenemos la oportunidad de disfrutar de 10 de los mejores cortometrajes producidos en España, de forma totalmente gratuita, en esta séptima edición del Festival de Cortos de La Nucía” afirma Pedro Lloret, concejal de Cultura.
CortoEspaña en La Nucía
CortoEspaña participa, organiza y colabora en más de cien festivales de cortometrajes en toda España, uno de los cuáles se celebra en La Nucía desde 2014. El objetivo de este Festival de Cortos de La Nucía se hacer llegar el cine y el mundo de los jóvenes creadores de cortometrajes a los espectadores de La Nucía y comarca.